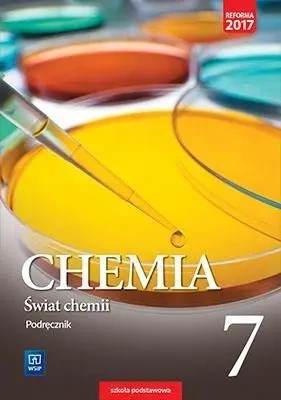

Chemia SP 7 Świat chemii Podr. WSiP - Anna Warchoł, Andrzej Danel, Dorota Lewandowska,
Promocja
Chemia SP 7 Świat chemii Podr. WSiP - Anna Warchoł, Andrzej Danel, Dorota Lewandowska,
Język przekazu dostosowany do wieku i poziomu umiejętności uczniów ułatwia zrozumienie chemii.
Treść przedzielono śródtytułami w formie pytań, aby wykład budził zaciekawienie. Odpowiedzi na pytania uczeń znajdzie w krótkich blokach tekstu. Taka forma, znana młodzieży z internetu, pozwala na zapoznawanie się z materiałem w odpowiednim tempie i nie wykracza poza możliwości percepcyjne nastolatków.
Każde doświadczenie jest uzupełnione o schematyczny rysunek i barwną fotografię, które w połączeniu z opisem pokazują krok po kroku jego przebieg. Uczniowie dokładnie widzą, co się dzieje podczas doświadczenia, nawet kiedy nie można go przeprowadzić w szkole.
Treść podręcznika odpowiada zapisom nowej podstawy programowej, zawiera wszystkie nowe zagadnienia przez nią wprowadzone, np. pojęcie elektroujemności czy katalizatora.
Część 1 publikacji dotyczy podstaw chemii opisuje: budowę materii i jej rodzaje; oddziaływania, których efektem są wiązania i reakcje chemiczne; substancje chemiczne obecne w atmosferze i hydrosferze.
Konstrukcja publikacji pozwala rozwijać zainteresowanie przedmiotem, m.in. dzięki wprowadzeniu wielu doświadczeń, w tym również do wykonania przez uczniów w domu. Zaproponowano także wiele doświadczeń w tym również do wykonania przez uczniów w domu dzięki czemu uczeń ma szansę kształcić umiejętności praktyczne.
Treść została podzielona na działy, w których znajdują się stałe elementy.
Graficzne wprowadzenie ma zainteresować materiałem omawianym w dziale.
Część główna tematu, podzielona na krótkie fragmenty rozpoczynające się pytaniem, przyciąga uwagę ilustrowanymi schematami i zdjęciami doświadczeń chemicznych.
Podsumowanie zawiera definicje nowych pojęć, które pozwalają szybko przypomnieć sobie najważniejsze terminy poznane podczas lekcji.
Na końcu każdego z tematów, pod hasłem Sprawdź, czy wiesz i rozumiesz, znajdują się pytania i zadania, dzięki którym uczeń oceni, w jakim stopniu zrozumiał problem omawiany w tekście.
W części Dowiedz się więcej zamieszczono pytania i polecenia prowokujące do wyszukiwania wiadomości, które w istotny sposób poszerzą wiedzę ucznia na temat otaczającego go świata.
Domowe laboratorium to propozycje prostych eksperymentów, które UCZEŃ może wykonać w domu za pomocą przedmiotów codziennego użytku, oczywiście PO UZYSKANIU ZGODY RODZICÓW.
Krótkie, ciekawe artykuły Czy wiesz, że z dziedziny ekologii, historii chemii i jej zastosowań mają zainteresować i sprowokować do poszukiwania dodatkowych informacji.
Bogato ilustrowane, zwięzłe Podsumowanie na koniec działu pomaga uporządkować i utrwalić zdobyte wiadomości, w myśl łacińskiej sentencji repetitio est mater studiorum, czyli: powtarzanie jest matką wiedzy.
Test wyboru Sprawdź się składa się z pytań testowych jednokrotnego wyboru (odpowiedzi znajdują się na końcu podręcznika). Uczeń ma możliwość samodzielnej ewaluacji wiedzy przed sprawdzianem.
Wprawki egzaminacyjne zawierają zadania sprawdzające opanowanie zagadnień opisanych w kolejnych punktach podstawy programowej. Nie dotyczą one treści omawianych jedynie w danym rozdziale, lecz pozwalają wracać do wcześniej zdobytych wiadomości i umiejętności.
Działy:
Rodzaje i przemiany materii
Budowa materii
Wiązania i reakcje chemiczne
Gazy
Woda i roztwory wodne
Na końcu każdej części podręcznika zamieszczono Test końcowy, który w klasie 7 składa się z 24 zadań sprawdzających.
EAN: 9788302168765
Najczęściej zadawane pytania
Co warto zrobić, jeżeli nasza pociecha nie może brać podręczników szkolnych do swojego domu?
Od jakiegoś czasu dzieci uczęszczające do szkół podstawowych dostają zupełnie darmowe komplety książek do lekcji od placówki edukacyjnej. Warto zauważyć, że w wielu miejscach dzieci mogą korzystać z nich wyłącznie w placówce i nie mogą przynosić książki do domu, żeby przypadkiem tam ich nie zniszczyć. Posiadanie własnej książki to duża wygoda – można się bezpośrednio z takiej książki uczyć i nie trzeba notować każdych ćwiczeń w zeszycie i się martwić czy aby na pewno właściwie się to zrobiło. Kiedy zamierzasz nieco uprościć naukę własnemu dziecku – zdecyduj się kupno odpowiednich podręczników, książek, z których uczeń będzie mógł użytkować swobodnie w domu.
Gdzie nabyć podręczniki do podstawówki?
W naszym bogatym asortymencie można natrafić na różnorakie przedmioty, w tym również podręczniki szkolne dla dzieci, które uczą się w szkole podstawowej w klasach 1-8. Od kilku lat uczniowie z podstawówki otrzymują nieodpłatnie książki do nauki – choć nie wszystkie. Proponujemy książki a także zeszyty z ćwiczeniami, które dzieci nie dostają za darmo. Posiadamy również nowe podręczniki, które można kupić w razie uszkodzenia lub zapodziania podręczników otrzymanych za darmo.
Marka
Symbol
249704
Rok wydania
2017
Strony
208
Oprawa
broszurowa
Format
17x24 cm
Nr dopuszczenia
834/1/2017
Klasa
SP 7
Data premiery
2019-08-05
Waga
378 g

Bez ryzyka
14 dni na łatwy zwrot

Szeroki asortyment
ponad milion pozycji

Niskie ceny i rabaty
nawet do 50% każdego dnia
Oszczędź kupując więcej

Świat chemii 7 Podręcznik + zeszyt ćwiczeń WSIP PAKIET - Anna Warchoł, Andrzej Danel, Dorota Lewandowska,
66,19 zł/1szt.
Niepotwierdzona zakupem
Ocena: /5
Marka
Podmiot odpowiedzialny za ten produkt na terenie UE
Wydawnictwa Szkolne i Pedagogiczne S.A.Więcej
Adres:
Al. Jerozolimskie 96Kod pocztowy: 00-807Miasto: WarszawaKraj: PolskaNumer telefonu: 22 422-30-01Adres email: wsip@wsip.com.pl
Symbol
249704
Kod producenta
9788302168765
Rok wydania
2017
Strony
208
Oprawa
broszurowa
Format
17x24 cm
Nr dopuszczenia
834/1/2017
Klasa
SP 7
Data premiery
2019-08-05
Autorzy
Anna Warchoł, Andrzej Danel, Dorota Lewandowska,
Waga
378 g

Podręcznik Świat chemii to chemia bez zawiłości ponieważ:
Język przekazu dostosowany do wieku i poziomu umiejętności uczniów ułatwia zrozumienie chemii.
Treść przedzielono śródtytułami w formie pytań, aby wykład budził zaciekawienie. Odpowiedzi na pytania uczeń znajdzie w krótkich blokach tekstu. Taka forma, znana młodzieży z internetu, pozwala na zapoznawanie się z materiałem w odpowiednim tempie i nie wykracza poza możliwości percepcyjne nastolatków.
Każde doświadczenie jest uzupełnione o schematyczny rysunek i barwną fotografię, które w połączeniu z opisem pokazują krok po kroku jego przebieg. Uczniowie dokładnie widzą, co się dzieje podczas doświadczenia, nawet kiedy nie można go przeprowadzić w szkole.
Treść podręcznika odpowiada zapisom nowej podstawy programowej, zawiera wszystkie nowe zagadnienia przez nią wprowadzone, np. pojęcie elektroujemności czy katalizatora.
Część 1 publikacji dotyczy podstaw chemii opisuje: budowę materii i jej rodzaje; oddziaływania, których efektem są wiązania i reakcje chemiczne; substancje chemiczne obecne w atmosferze i hydrosferze.
Konstrukcja publikacji pozwala rozwijać zainteresowanie przedmiotem, m.in. dzięki wprowadzeniu wielu doświadczeń, w tym również do wykonania przez uczniów w domu. Zaproponowano także wiele doświadczeń w tym również do wykonania przez uczniów w domu dzięki czemu uczeń ma szansę kształcić umiejętności praktyczne.
Treść została podzielona na działy, w których znajdują się stałe elementy.
Graficzne wprowadzenie ma zainteresować materiałem omawianym w dziale.
Część główna tematu, podzielona na krótkie fragmenty rozpoczynające się pytaniem, przyciąga uwagę ilustrowanymi schematami i zdjęciami doświadczeń chemicznych.
Podsumowanie zawiera definicje nowych pojęć, które pozwalają szybko przypomnieć sobie najważniejsze terminy poznane podczas lekcji.
Na końcu każdego z tematów, pod hasłem Sprawdź, czy wiesz i rozumiesz, znajdują się pytania i zadania, dzięki którym uczeń oceni, w jakim stopniu zrozumiał problem omawiany w tekście.
W części Dowiedz się więcej zamieszczono pytania i polecenia prowokujące do wyszukiwania wiadomości, które w istotny sposób poszerzą wiedzę ucznia na temat otaczającego go świata.
Domowe laboratorium to propozycje prostych eksperymentów, które UCZEŃ może wykonać w domu za pomocą przedmiotów codziennego użytku, oczywiście PO UZYSKANIU ZGODY RODZICÓW.
Krótkie, ciekawe artykuły Czy wiesz, że z dziedziny ekologii, historii chemii i jej zastosowań mają zainteresować i sprowokować do poszukiwania dodatkowych informacji.
Bogato ilustrowane, zwięzłe Podsumowanie na koniec działu pomaga uporządkować i utrwalić zdobyte wiadomości, w myśl łacińskiej sentencji repetitio est mater studiorum, czyli: powtarzanie jest matką wiedzy.
Test wyboru Sprawdź się składa się z pytań testowych jednokrotnego wyboru (odpowiedzi znajdują się na końcu podręcznika). Uczeń ma możliwość samodzielnej ewaluacji wiedzy przed sprawdzianem.
Wprawki egzaminacyjne zawierają zadania sprawdzające opanowanie zagadnień opisanych w kolejnych punktach podstawy programowej. Nie dotyczą one treści omawianych jedynie w danym rozdziale, lecz pozwalają wracać do wcześniej zdobytych wiadomości i umiejętności.
Działy:
Rodzaje i przemiany materii
Budowa materii
Wiązania i reakcje chemiczne
Gazy
Woda i roztwory wodne
Na końcu każdej części podręcznika zamieszczono Test końcowy, który w klasie 7 składa się z 24 zadań sprawdzających.
EAN: 9788302168765
Co warto zrobić, jeżeli nasza pociecha nie może brać podręczników szkolnych do swojego domu?
Od jakiegoś czasu dzieci uczęszczające do szkół podstawowych dostają zupełnie darmowe komplety książek do lekcji od placówki edukacyjnej. Warto zauważyć, że w wielu miejscach dzieci mogą korzystać z nich wyłącznie w placówce i nie mogą przynosić książki do domu, żeby przypadkiem tam ich nie zniszczyć. Posiadanie własnej książki to duża wygoda – można się bezpośrednio z takiej książki uczyć i nie trzeba notować każdych ćwiczeń w zeszycie i się martwić czy aby na pewno właściwie się to zrobiło. Kiedy zamierzasz nieco uprościć naukę własnemu dziecku – zdecyduj się kupno odpowiednich podręczników, książek, z których uczeń będzie mógł użytkować swobodnie w domu.
Gdzie nabyć podręczniki do podstawówki?
W naszym bogatym asortymencie można natrafić na różnorakie przedmioty, w tym również podręczniki szkolne dla dzieci, które uczą się w szkole podstawowej w klasach 1-8. Od kilku lat uczniowie z podstawówki otrzymują nieodpłatnie książki do nauki – choć nie wszystkie. Proponujemy książki a także zeszyty z ćwiczeniami, które dzieci nie dostają za darmo. Posiadamy również nowe podręczniki, które można kupić w razie uszkodzenia lub zapodziania podręczników otrzymanych za darmo.
Język przekazu dostosowany do wieku i poziomu umiejętności uczniów ułatwia zrozumienie chemii.
Treść przedzielono śródtytułami w formie pytań, aby wykład budził zaciekawienie. Odpowiedzi na pytania uczeń znajdzie w krótkich blokach tekstu. Taka forma, znana młodzieży z internetu, pozwala na zapoznawanie się z materiałem w odpowiednim tempie i nie wykracza poza możliwości percepcyjne nastolatków.
Każde doświadczenie jest uzupełnione o schematyczny rysunek i barwną fotografię, które w połączeniu z opisem pokazują krok po kroku jego przebieg. Uczniowie dokładnie widzą, co się dzieje podczas doświadczenia, nawet kiedy nie można go przeprowadzić w szkole.
Treść podręcznika odpowiada zapisom nowej podstawy programowej, zawiera wszystkie nowe zagadnienia przez nią wprowadzone, np. pojęcie elektroujemności czy katalizatora.
Część 1 publikacji dotyczy podstaw chemii opisuje: budowę materii i jej rodzaje; oddziaływania, których efektem są wiązania i reakcje chemiczne; substancje chemiczne obecne w atmosferze i hydrosferze.
Konstrukcja publikacji pozwala rozwijać zainteresowanie przedmiotem, m.in. dzięki wprowadzeniu wielu doświadczeń, w tym również do wykonania przez uczniów w domu. Zaproponowano także wiele doświadczeń w tym również do wykonania przez uczniów w domu dzięki czemu uczeń ma szansę kształcić umiejętności praktyczne.
Treść została podzielona na działy, w których znajdują się stałe elementy.
Graficzne wprowadzenie ma zainteresować materiałem omawianym w dziale.
Część główna tematu, podzielona na krótkie fragmenty rozpoczynające się pytaniem, przyciąga uwagę ilustrowanymi schematami i zdjęciami doświadczeń chemicznych.
Podsumowanie zawiera definicje nowych pojęć, które pozwalają szybko przypomnieć sobie najważniejsze terminy poznane podczas lekcji.
Na końcu każdego z tematów, pod hasłem Sprawdź, czy wiesz i rozumiesz, znajdują się pytania i zadania, dzięki którym uczeń oceni, w jakim stopniu zrozumiał problem omawiany w tekście.
W części Dowiedz się więcej zamieszczono pytania i polecenia prowokujące do wyszukiwania wiadomości, które w istotny sposób poszerzą wiedzę ucznia na temat otaczającego go świata.
Domowe laboratorium to propozycje prostych eksperymentów, które UCZEŃ może wykonać w domu za pomocą przedmiotów codziennego użytku, oczywiście PO UZYSKANIU ZGODY RODZICÓW.
Krótkie, ciekawe artykuły Czy wiesz, że z dziedziny ekologii, historii chemii i jej zastosowań mają zainteresować i sprowokować do poszukiwania dodatkowych informacji.
Bogato ilustrowane, zwięzłe Podsumowanie na koniec działu pomaga uporządkować i utrwalić zdobyte wiadomości, w myśl łacińskiej sentencji repetitio est mater studiorum, czyli: powtarzanie jest matką wiedzy.
Test wyboru Sprawdź się składa się z pytań testowych jednokrotnego wyboru (odpowiedzi znajdują się na końcu podręcznika). Uczeń ma możliwość samodzielnej ewaluacji wiedzy przed sprawdzianem.
Wprawki egzaminacyjne zawierają zadania sprawdzające opanowanie zagadnień opisanych w kolejnych punktach podstawy programowej. Nie dotyczą one treści omawianych jedynie w danym rozdziale, lecz pozwalają wracać do wcześniej zdobytych wiadomości i umiejętności.
Działy:
Rodzaje i przemiany materii
Budowa materii
Wiązania i reakcje chemiczne
Gazy
Woda i roztwory wodne
Na końcu każdej części podręcznika zamieszczono Test końcowy, który w klasie 7 składa się z 24 zadań sprawdzających.
EAN: 9788302168765
Najczęściej zadawane pytania
Co warto zrobić, jeżeli nasza pociecha nie może brać podręczników szkolnych do swojego domu?
Od jakiegoś czasu dzieci uczęszczające do szkół podstawowych dostają zupełnie darmowe komplety książek do lekcji od placówki edukacyjnej. Warto zauważyć, że w wielu miejscach dzieci mogą korzystać z nich wyłącznie w placówce i nie mogą przynosić książki do domu, żeby przypadkiem tam ich nie zniszczyć. Posiadanie własnej książki to duża wygoda – można się bezpośrednio z takiej książki uczyć i nie trzeba notować każdych ćwiczeń w zeszycie i się martwić czy aby na pewno właściwie się to zrobiło. Kiedy zamierzasz nieco uprościć naukę własnemu dziecku – zdecyduj się kupno odpowiednich podręczników, książek, z których uczeń będzie mógł użytkować swobodnie w domu.
Gdzie nabyć podręczniki do podstawówki?
W naszym bogatym asortymencie można natrafić na różnorakie przedmioty, w tym również podręczniki szkolne dla dzieci, które uczą się w szkole podstawowej w klasach 1-8. Od kilku lat uczniowie z podstawówki otrzymują nieodpłatnie książki do nauki – choć nie wszystkie. Proponujemy książki a także zeszyty z ćwiczeniami, które dzieci nie dostają za darmo. Posiadamy również nowe podręczniki, które można kupić w razie uszkodzenia lub zapodziania podręczników otrzymanych za darmo.
Niepotwierdzona zakupem
Ocena: /5
Zapytaj o produkt
Niepotwierdzona zakupem
Ocena: /5
Napisz swoją opinię